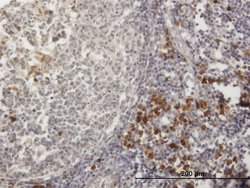
TXNDC5, Mouse anti-Human, Polyclonal Antibody, Abnova 50&mu;g; Unconjugated:Antibodies,

missing translation for 'onlineSavingsMsg'
Learn More
Learn More
TXNDC5, Mouse anti-Human, Polyclonal Antibody, Abnova™
Mouse Polyclonal Antibody
Brand: Abnova H00081567-B01P.50ug
This item is not returnable.
View return policy
Description
Sequence: MTQSVDSNRGNRNEKRCGHCQRLQPTWNDLGDKYNSMEDAKVYVAKVDCTAHSDVCSAQGVRGYPTLKLFKPGQEAVKYQGPRDFQTLENWMLQTLNEEPVTPEPEVEPPSAPELKQGLYELSASNFELHVAQGDHFIKFFAPWCGHCKALAPTWEQLALGLEHSETVKIGKVDCTQHYELCSGNQVRGYPTLLWFRDGKKVDQYKGKRDLESLREYVESQLQRTETGATETVTPSEAPVLAAEPEADKGTVLALTENNFDDTIAEGITFIKFYAPWCGHCKTLAPTWEELSKKEFPGLAGVKIAEVDCTAERNICSKYSVRGYPTLLLFRGGKKVSEHSGGRDLDSLHRFVLSQAKDELSpecifications
| TXNDC5 | |
| Polyclonal | |
| In 1x PBS, pH 7.4 | |
| BC052310.1 | |
| TXNDC5 | |
| TXNDC5 (AAH52310.1, 1 a.a. ∼ 360 a.a) full-length human protein. | |
| RUO | |
| 81567 | |
| Store at -20°C or lower. Aliquot to avoid repeated freezing and thawing. | |
| Purified |
| Immunofluorescence, Immunohistochemistry (Paraffin), Western Blot | |
| Unconjugated | |
| thioredoxin domain containing 5 | |
| ERP46/EndoPDI/Hcc-2/MGC3178/UNQ364 | |
| Mouse | |
| 50 μg | |
| Primary | |
| Human | |
| Antibody |
Product Content Correction
Your input is important to us. Please complete this form to provide feedback related to the content on this product.
Product Title
Spot an opportunity for improvement?Share a Content Correction